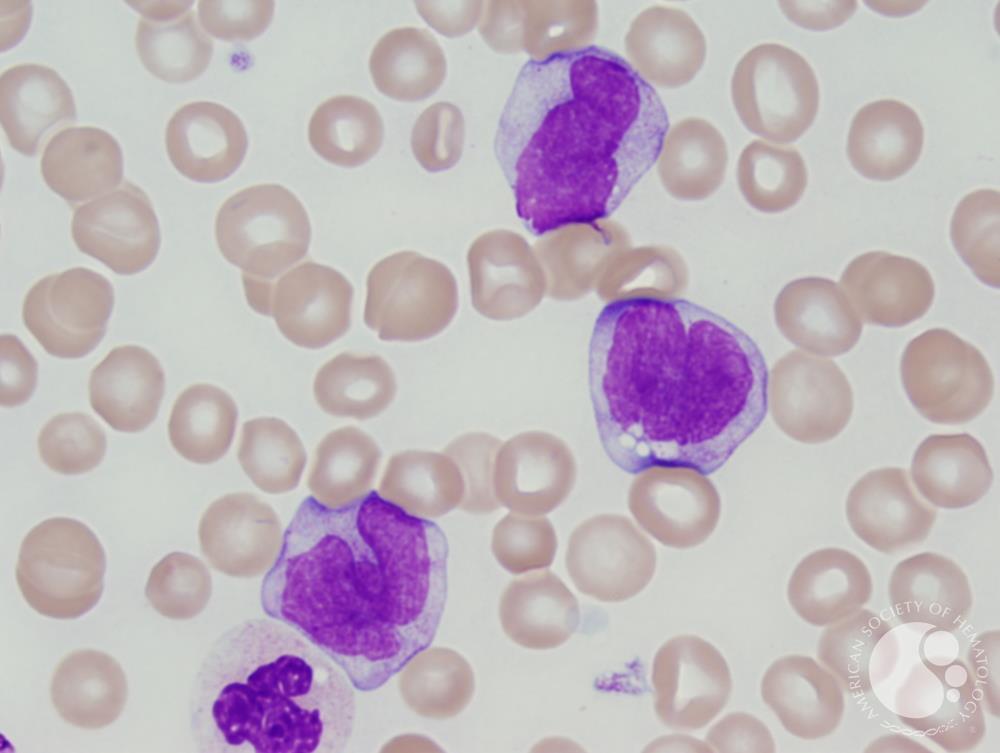
Chronic myelomonocytic leukemia 1 CMML 1 1 Chronic myelomonocytic leukemia 1 CMML 1 1

Konsep 40+ Chronic Leukemia
Konsep 40+ Chronic Leukemia. Tapi masalahnya, mempunyai sebuah rumah bukanlah hal yang mudah, untuk mempunyai sebuah rumah yang enak anda membutuhkan banyak biaya , ditambah lagi harga tanah di daerah perkotaan semakin mahal sebab lahannya semakin lama semakin sedikit. Lagipula harga bahan bangunan yang juga ikut-ikutan meroket akhir-akhir ini. Sudah pasti dengan bajet yang lumayan besar, untuk membangun sebuah rumah besar yang nyaman tentu akan sedikit sulit. Simak ulasan terkait obat sehat dengan artikel Konsep 40+ Chronic Leukemia berikut ini

Chronic lymphocytic leukemia Wikipedia Sumber en.wikipedia.org

Chronic myeloid leukemia Sumber www.slideshare.net

Chronic Leukemia causes symptoms diagnosis treatment Sumber www.youtube.com

Acute myeloid leukemia Wikipedia Sumber en.wikipedia.org

Chronic Myelomonocytic Leukemia 3 Sumber imagebank.hematology.org
Chronic myelomonocytic leukemia 1 CMML 1 1 Sumber imagebank.hematology.org

Chronic leukemia Sumber www.slideshare.net

Mice pave the way to a cord blood transplant advance Sumber speakingofresearch.com

Chronic Myelomonocytic Leukemia 1 Sumber imagebank.hematology.org

Chronic Myelomonocytic Leukemia 6 Sumber imagebank.hematology.org

Chronic myelogenous leukemia Wikipedia Sumber en.wikipedia.org

Chronic myelogenous leukemia Wikipedia Sumber en.wikipedia.org

Basophilic blast phase of chronic myelogenous leukemia Sumber imagebank.hematology.org

Leukemia one of bad cancer Health and Care Sumber infomationhealth.blogspot.com

Soubor Chronic Lymphocytic Leukemia jpg Wikipedie Sumber cs.wikipedia.org

Chronic lymphocytic leukemia Wikipedia Sumber en.wikipedia.org
What Is Chronic Lymphocytic Leukemia
10 05 2020 Chronic lymphocytic leukemia CLL is the most common leukemia in adults It s a type of cancer that starts in cells that become certain white blood cells called lymphocytes in the bone marrow The cancer leukemia cells start in the bone marrow but then go into the blood

Chronic myeloid leukemia Sumber www.slideshare.net
Chronic vs Acute Leukemia What s the Difference
08 07 2020 Chronic leukemia is most commonly diagnosed after a routine blood test You may have low level symptoms for years before it s diagnosed The symptoms may be

Chronic Leukemia causes symptoms diagnosis treatment Sumber www.youtube.com
Chronic lymphocytic leukaemia NHS
19 06 2020 Chronic myeloid leukemia is a type of cancer that starts in the blood forming cells of the bone marrow Learn more about chronic myeloid leukemia here
Acute myeloid leukemia Wikipedia Sumber en.wikipedia.org
What Is Chronic Myeloid Leukemia Leukemia Types
What Is Chronic Lymphocytic Leukemia Chronic lymphocytic leukemia CLL is a cancer that affects a type of white blood cell called a lymphocyte Lymphocytes help your body fight infection They
Chronic Myelomonocytic Leukemia 3 Sumber imagebank.hematology.org
Chronic myelogenous leukemia Wikipedia
Chronic lymphocytic leukemia is a type of cancer in which the bone marrow makes too many lymphocytes a type of white blood cell Chronic lymphocytic leukemia also called CLL is a blood and bone marrow disease that usually gets worse slowly CLL is one of the most common types of leukemia in adults It often occurs during or after middle age it rarely occurs in children
Chronic myelomonocytic leukemia 1 CMML 1 1 Sumber imagebank.hematology.org
Chronic Lymphocytic Leukemia Causes Symptoms Treatment
Chronic lymphocytic leukemia CLL is a type of cancer that affects the blood and bone marrow Bone marrow is a soft spongy substance within bones that produces blood cells CLL is the result of

Chronic leukemia Sumber www.slideshare.net
Chronic lymphocytic leukemia Symptoms and causes Mayo
Mice pave the way to a cord blood transplant advance Sumber speakingofresearch.com
Chronic Lymphocytic Leukemia Treatment PDQ Patient
Chronic Myelomonocytic Leukemia 1 Sumber imagebank.hematology.org
Chronic Lymphocytic Leukemia Survival Rates and Outlook
Chronic Myelomonocytic Leukemia 6 Sumber imagebank.hematology.org
Chronic lymphocytic leukemia Wikipedia

Chronic myelogenous leukemia Wikipedia Sumber en.wikipedia.org
Chronic myelogenous leukemia Wikipedia Sumber en.wikipedia.org
Basophilic blast phase of chronic myelogenous leukemia Sumber imagebank.hematology.org

Leukemia one of bad cancer Health and Care Sumber infomationhealth.blogspot.com
Soubor Chronic Lymphocytic Leukemia jpg Wikipedie Sumber cs.wikipedia.org
0 Comments